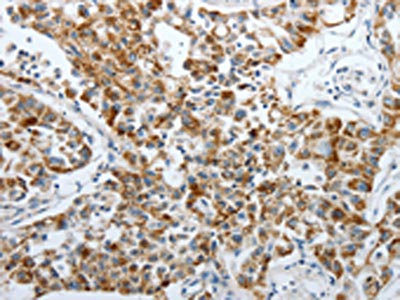

PDK2 Antibody
-
中文名稱:PDK2兔多克隆抗體
-
貨號(hào):CSB-PA656448
-
規(guī)格:¥1100
-
圖片:
-
The image on the left is immunohistochemistry of paraffin-embedded Human liver cancer tissue using CSB-PA656448(PDK2 Antibody) at dilution 1/40, on the right is treated with synthetic peptide. (Original magnification: ×200)
-
The image on the left is immunohistochemistry of paraffin-embedded Human lung cancer tissue using CSB-PA656448(PDK2 Antibody) at dilution 1/40, on the right is treated with synthetic peptide. (Original magnification: ×200)
-
Gel: 10%SDS-PAGE, Lysate: 50 μg, Lane: Mouse heart tissue, Primary antibody: CSB-PA656448(PDK2 Antibody) at dilution 1/500, Secondary antibody: Goat anti rabbit IgG at 1/8000 dilution, Exposure time: 1 minute
-
-
其他:
產(chǎn)品詳情
-
Uniprot No.:
-
基因名:
-
別名:[Pyruvate dehydrogenase [lipoamide]] kinase isozyme 2 antibody; mitochondrial antibody; PDHK2 antibody; PDK2 antibody; PDK2_HUMAN antibody; Pyruvate dehydrogenase kinase isoform 2 antibody; Pyruvate dehydrogenase kinase, isozyme 2 antibody; Pyruvate dehydrogenase lipoamide kinase isozyme 2, mitochondrial antibody
-
宿主:Rabbit
-
反應(yīng)種屬:Human,Mouse,Rat
-
免疫原:Synthetic peptide of Human PDK2
-
免疫原種屬:Homo sapiens (Human)
-
標(biāo)記方式:Non-conjugated
-
抗體亞型:IgG
-
純化方式:Antigen affinity purification
-
濃度:It differs from different batches. Please contact us to confirm it.
-
保存緩沖液:-20°C, pH7.4 PBS, 0.05% NaN3, 40% Glycerol
-
產(chǎn)品提供形式:Liquid
-
應(yīng)用范圍:ELISA,WB,IHC
-
推薦稀釋比:
Application Recommended Dilution ELISA 1:1000-1:2000 WB 1:200-1:1000 IHC 1:50-1:200 -
Protocols:
-
儲(chǔ)存條件:Upon receipt, store at -20°C or -80°C. Avoid repeated freeze.
-
貨期:Basically, we can dispatch the products out in 1-3 working days after receiving your orders. Delivery time maybe differs from different purchasing way or location, please kindly consult your local distributors for specific delivery time.
-
用途:For Research Use Only. Not for use in diagnostic or therapeutic procedures.
相關(guān)產(chǎn)品
靶點(diǎn)詳情
-
功能:Kinase that plays a key role in the regulation of glucose and fatty acid metabolism and homeostasis via phosphorylation of the pyruvate dehydrogenase subunits PDHA1 and PDHA2. This inhibits pyruvate dehydrogenase activity, and thereby regulates metabolite flux through the tricarboxylic acid cycle, down-regulates aerobic respiration and inhibits the formation of acetyl-coenzyme A from pyruvate. Inhibition of pyruvate dehydrogenase decreases glucose utilization and increases fat metabolism. Mediates cellular responses to insulin. Plays an important role in maintaining normal blood glucose levels and in metabolic adaptation to nutrient availability. Via its regulation of pyruvate dehydrogenase activity, plays an important role in maintaining normal blood pH and in preventing the accumulation of ketone bodies under starvation. Plays a role in the regulation of cell proliferation and in resistance to apoptosis under oxidative stress. Plays a role in p53/TP53-mediated apoptosis.
-
基因功能參考文獻(xiàn):
- PDK2/PARL senses defects in mitochondrial bioenergetics. PMID: 28178523
- The data demonstrate potential roles of PDK2 and ABCG2 polymorphisms in the metabolic phenotypes of Tibetan gout patients. PMID: 26909964
- High glycolysis and PDK2 overexpression are closely linked to cisplatin resistance in head and neck cancer cells, which can be reversed by PDK2 nhibition. PMID: 26607904
- The findings of the present study reveal a novel survival pathway that functionally couples the unique glycolytic phenotype in cancer cells to hypoxia resistance via a PDK2-dependent mechanism that switches Bnip3 from cell death to survival. PMID: 26416963
- The final compound of this series, 2-[(2,4-dihydroxyphenyl)sulfonyl]isoindoline-4,6-diol, designated PS10, inhibits all four PDK isoforms with IC50 = 0.8 muM for PDK2. PMID: 24356970
- Germline mutations in PKD2 gene is associated with autosomal-dominant polycystic kidney disease. PMID: 23300259
- we for the first time demonstrated that a low-nutrient condition drives cancer cells to utilize glycolysis to produce ATP, and this increases the Warburg effect through a novel mechanism involving ROS/AMPK-dependent activation of PDK. PMID: 23376776
- Mitochondrial activation by inhibition of PDKII suppresses HIF1a signaling and angiogenesis in cancer. PMID: 22614004
- Inactivation of pyruvate dehydrogenase kinase 2 by mitochondrial reactive oxygen species. PMID: 22910903
- Results established that wild-type p53 prevents manifestation of the Warburg effect by controlling Pdk2. These findings elucidate a new mechanism by which p53 suppresses tumorigenesis acting at the level of cancer cell metabolism. PMID: 22123926
- PKD2 mutations are associated with autosomal dominant polycystic kidney disease. PMID: 21115670
- study of facilitated interaction between the pyruvate dehydrogenase kinase isoform 2 and the dihydrolipoyl acetyltransferase PMID: 12816949
- The increased PDK activity was independent of changes in intra-mitochondrial effectors, and PDK-2 and PDK-4 protein content, suggesting that it was caused by a change in the specific activity of the existing kinases. PMID: 15169745
- A mechanism for pyruvate dehydrogenase kinase isoform 2 regulation is supported in which kinase activity is limited by ADP dissociation and pyruvate binding. PMID: 15491150
- Reductive acetylation stimulates activity of pyruvate dehydrogenase kinase isoform 2 by speeding up ADP dissociation. PMID: 15491151
- in human muscle, hormonal and nutritional conditions may control PDK2 and PDK4 mRNA expression via a common signalling mechanism. PMID: 15955060
- Crystallographic studies reveal several PDHK2 structures with C-terminal cross arms that span a large trough region between the N-terminal regulatory (R) domains of the PDHK2 dimers. Three novel ligand binding sites are located in the R domain of PDHK2. PMID: 16401071
- analysis of ligand induced effects on pyruvate dehydrogenase kinase isoform 2 PMID: 16517984
- These studies identify ORP9 as a PDK-2 substrate and negative regulator of Akt phosphorylation at the PDK-2 site. PMID: 16962287
- PDK2, PDK3 and PDK4 are primary PPARbeta/delta target genes in humans underlining the importance of the receptor in the control of metabolism PMID: 17669420
- Critical role of specific ions for ligand-induced changes regulating pyruvate dehydrogenase kinase isoform 2. PMID: 18220414
- Pi is suggested to facilitate transmission within PDHK2 of the stimulatory signal of acetylation from the distal lipoyl-group binding site to the active site. PMID: 18220415
- mitochondrial ND2 mutation contributes to HIF1alpha accumulation via increased ROS production, up-regulation of PDK2, attenuating PDH activity, thereby increasing pyruvate, resulting in HIF1alpha stabilization PMID: 19147752
- PKD1 children have more and larger renal cysts, larger kidneys and higher ambulatory BP than do PKD2 children. PMID: 19194729
- the DW-motif has a pivotal role in mediating communications between the DCA-, the nucleotide-, and the lipoyl domain-binding sites of PDK2 PMID: 19833728
顯示更多
收起更多
-
亞細(xì)胞定位:Mitochondrion matrix.
-
蛋白家族:PDK/BCKDK protein kinase family
-
組織特異性:Expressed in many tissues, with the highest level in heart and skeletal muscle, intermediate levels in brain, kidney, pancreas and liver, and low levels in placenta and lung.
-
數(shù)據(jù)庫(kù)鏈接:
Most popular with customers
-
-
YWHAB Recombinant Monoclonal Antibody
Applications: ELISA, WB, IHC, IF, FC
Species Reactivity: Human, Mouse, Rat
-
Phospho-YAP1 (S127) Recombinant Monoclonal Antibody
Applications: ELISA, WB, IHC
Species Reactivity: Human
-
-
-
-
-